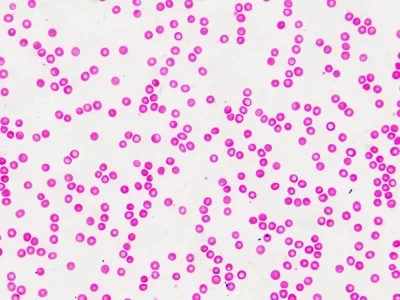

1
/
von
9
Martinair007
30 Dauerpräparate (Mensch)
30 Dauerpräparate (Mensch)
Normaler Preis
€34,90 EUR
Normaler Preis
Verkaufspreis
€34,90 EUR
Inkl. Steuern.
Anzahl
Verfügbarkeit für Abholungen konnte nicht geladen werden
Entdecken Sie mit diesen Dauerpräparaten den Menschen.
Diese Sammlung an Präparaten ermöglicht Ihnen einen perfekten Einstieg in die Mikroskopie. Es enthält 30 unterschiedliche Musterpräparate zur Histologie:
LIEFERUMFANG
Diese Sammlung an Präparaten ermöglicht Ihnen einen perfekten Einstieg in die Mikroskopie. Es enthält 30 unterschiedliche Musterpräparate zur Histologie:
- Lockeres Bindegewebe
- Hyalinknorpel
- Knorpel (elastisch)
- Rückenmark
- Schlüsselbein
- Knochen (dicht)
- Gereizter Muskel
- Skelettmuskel
- Sprungsehne (Kaninchen)
- Plattenepithel Mundschleimhaut
- Einschichtiges Ephitel
- Drüsengewebe (geschichtet)
- Flimmerepithel
- Menschliche Haut, Schnitt durch Haarfollikel
- Menschliche Haut, Schnitt durch Schweißdrüse
- Lunge
- Lunge mit Blutgefäßen
- Niere mit Blutgefäßen
- Arterie & Vene
- Menschliches Blut (Ausstrich)
- Lymphknoten
- Schilddrüse
- Magenwand
- Dünndarm
- Leber
- Herzmuskel
- Hoden
- Eierstock
- Niere
- Human-Chromosom
LIEFERUMFANG
- 30 Dauerpräparate
- Kunststoffbox mit Platz für 100 Präparate
Share